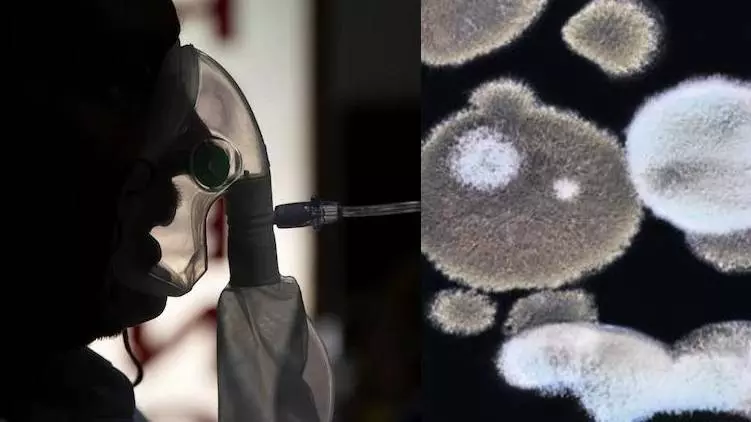
സംസ്ഥാനത്ത് ബ്ലാക്ക് ഫംഗസ് മരുന്ന് ക്ഷാമം രൂക്ഷം

സംസ്ഥാനത്ത് ബ്ലാക്ക് ഫംഗസ് മരുന്ന് ക്ഷാമം രൂക്ഷം
മെഡിക്കൽ കോർപറേഷന്റെ പക്കലും മരുന്ന് സ്റ്റോക്കില്ല
സംസ്ഥാനത്ത് ബ്ലാക്ക് ഫംഗസ് രോഗികൾ നൽകുന്ന മരുന്നിന് ക്ഷാമം. മെഡിക്കൽ കോർപറേഷന്റെ പക്കലും മരുന്ന് സ്റ്റോക്കില്ല. മരുന്ന് ക്ഷാമം പരിഹരിക്കാൻ ഇടപെടണമെന്ന് സംസ്ഥാനം കേന്ദ്രത്തോട് ആവശ്യപ്പെട്ടു.
പ്രമേഹം ഉൾപ്പെടെയുള്ള ഗുരുതര രോഗമുള്ള ബ്ലാക്ക് ഫംഗസ് ബാധിതർക്ക് നൽകുന്ന ലൈപോ സോമൽ ആംപോടെറിസിൻ ഇഞ്ചക്ഷൻ സംസ്ഥാനത്ത് സ്റ്റോക്കില്ല. തിരുവനന്തപുരം, മഞ്ചേരി, കോഴിക്കോട്, എറണാകുളം മെഡിക്കൽ കോളേജുകളിലും മരുന്നില്ല. സ്വകാര്യ ആശുപത്രികളിലും സ്റ്റോക്കില്ല. . നേരത്തെ തിരുവനന്തപുരം എസ്എടി ആശുപത്രിയിൽ നിന്നാണ് മരുന്ന് എത്തിച്ചിരുന്നത്. മെഡിക്കൽ കോർപറേഷന്റെ പക്കലും മരുന്ന് സ്റ്റോക്കില്ല. അതേസമയം, ആംപോടെറിസിൻ ബി ഇഞ്ചക്ഷൻ സ്റ്റോക്കുണ്ട്. ഗുരുതര രോഗികൾക്ക് ഈ മരുന്ന് നൽകുന്നത് വൃക്കയുടെ പ്രവർത്തനത്തെ ബാധിക്കും.
അതുകൊണ്ട് ഈ മരുന്ന് നൽകാനാവില്ല. സംസ്ഥാനങ്ങൾക്ക് കേന്ദ്രം നേരിട്ടാണ് മരുന്ന് വിതരണം ചെയ്യുന്നത്. 220 വയൽ മരുന്നാണ് സംസ്ഥാനം ആവശ്യപ്പെട്ടത്. രോഗികൾ കൂടിയ സാഹചര്യത്തിൽ എല്ലാ സംസ്ഥാനങ്ങളിലും ലൈപോ സോമൽ ആംപോടെറിസിൻ മരുന്ന് കടുത്ത ക്ഷാമം നേരിടുന്നു. അനുമതിയുള്ള കമ്പനികൾ ഉത്പാദനം വേഗത്തിലാക്കിയാൽ മാത്രമേ മരുന്ന് ക്ഷാമം പരിഹരിക്കാനാവൂ.
Adjust Story Font
16

